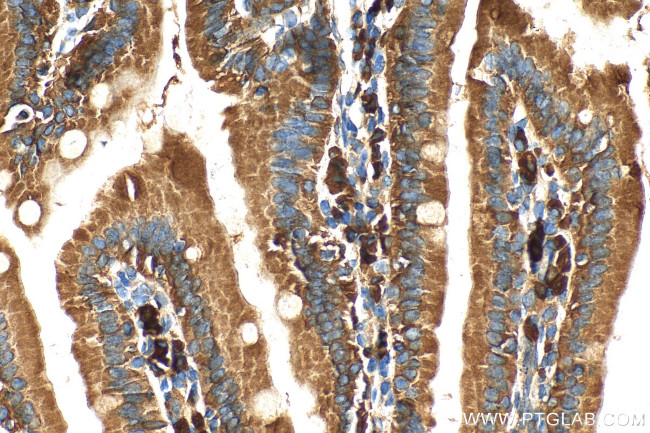
GPR124 Antibody in Immunohistochemistry (Paraffin) (IHC (P))

Search
Proteintech
GPR124 Polyclonal Antibody
{{$productOrderCtrl.translations['antibody.pdp.commerceCard.promotion.promotions']}}
{{$productOrderCtrl.translations['antibody.pdp.commerceCard.promotion.viewpromo']}}
{{$productOrderCtrl.translations['antibody.pdp.commerceCard.promotion.promocode']}}: {{promo.promoCode}} {{promo.promoTitle}} {{promo.promoDescription}}. {{$productOrderCtrl.translations['antibody.pdp.commerceCard.promotion.learnmore']}}
产品信息
20050-1-AP
种属反应
宿主/亚型
分类
类型
抗原
偶联物
形式
浓度
规格
纯化类型
保存液
内含物
保存条件
运输条件
靶标信息
Tumor endothelial markers (TEMs) are significantly up-regulated during angiogenesis and neoangiogensis that are crucial for the growth of solid tumors. TEMs localized on the cell surface and conserved across species are of particular interest for future development of anti-angiogenic therapies. These include TEMs such as TEM1, TEM5, TEM7 and TEM8. TEM5 is a member of the adhesion family of G protein coupled receptors and is localized on the surface of endothelial cells. TEM5 is a seven-pass transmembrane receptor, unlike TEM1, TEM7 and TEM8 which span the membrane once. TEM5 is abundantly expressed in tumor vessels, heart, placenta, ovary, small intestine, and colon. Proteolytically processed soluble TEM5 mediates endothelial cell survival during angiogenesis by linking integrin to glycosaminoglycans.
仅用于科研。不用于诊断过程。未经明确授权不得转售。
篇参考文献 (0)
生物信息学
蛋白别名: Adhesion G protein-coupled receptor A2; DKFZp434C211; DKFZp434J0911; FLJ14390; G protein-coupled receptor 124; G-protein coupled receptor 124; seven-pass transmembrane protein; Tumor endothelial marker 5; unnamed protein product
基因别名: 8430414O08Rik; 9530074E10Rik; ADGRA2; GPR124; KIAA1531; mKIAA1531; TEM5
UniProt ID: (Human) Q96PE1, (Mouse) Q91ZV8
Entrez Gene ID: (Human) 25960, (Mouse) 78560